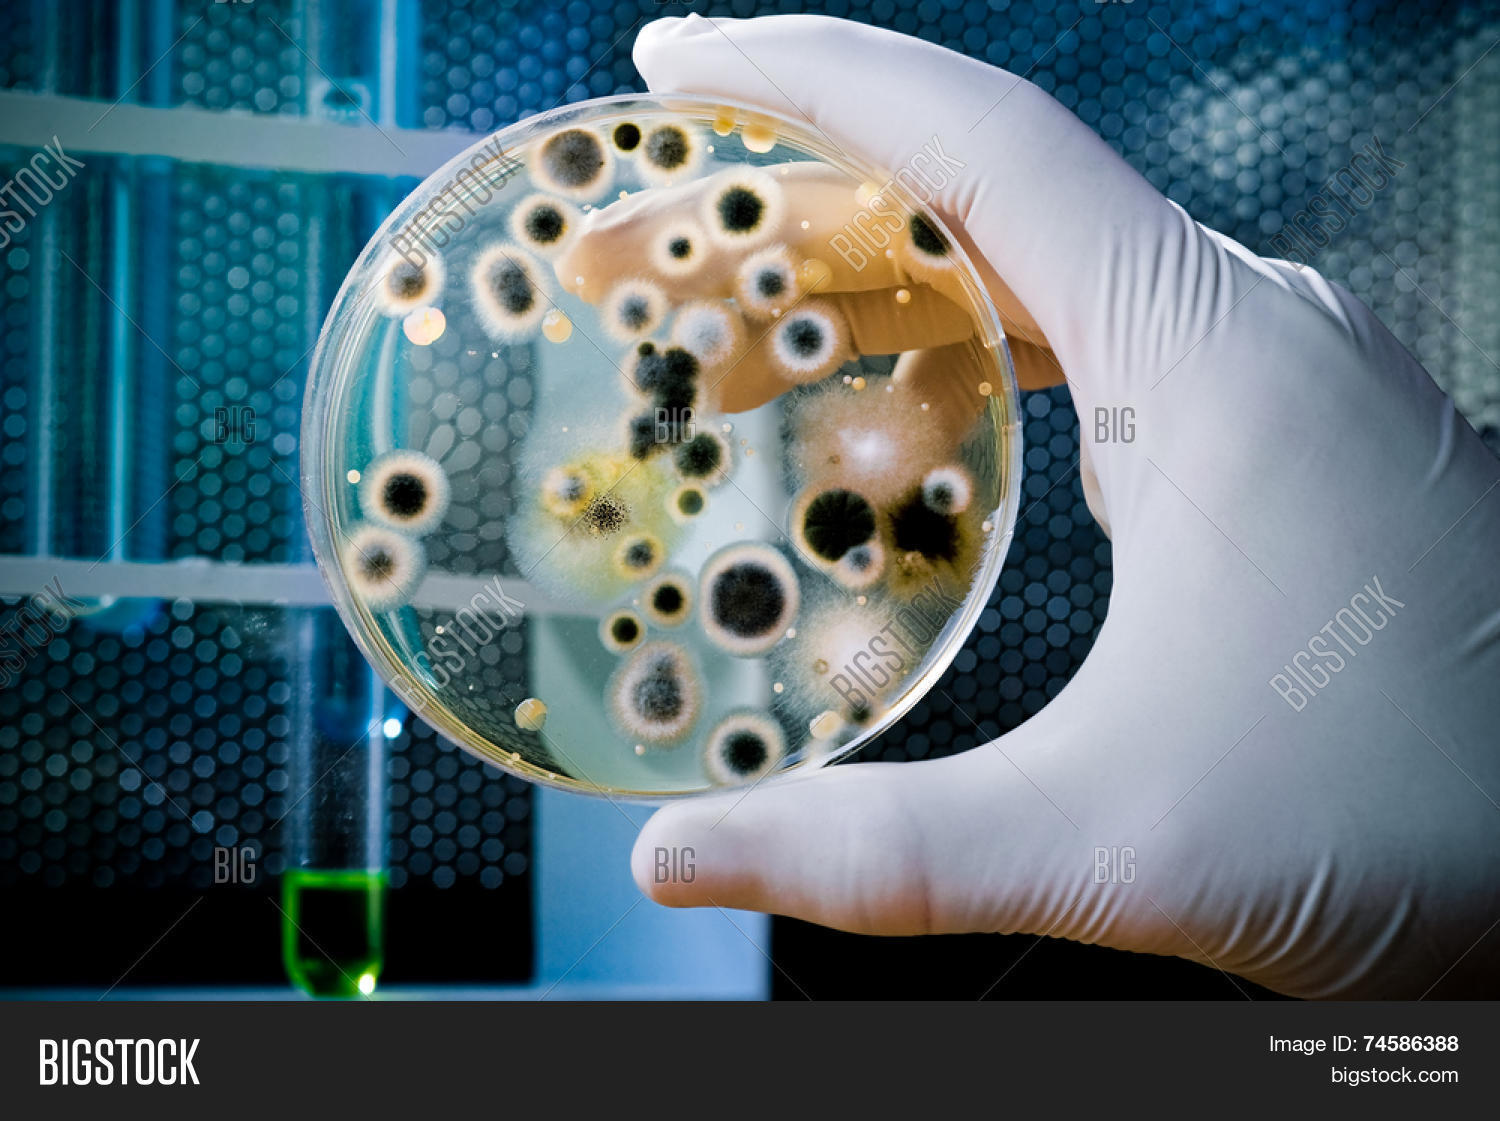

Биологические бактерии в воде
Погода села сейм
Вайша раяна
Зарплата няни в садике
Ин ту армс
Бисакодил свечи для чего применяют взрослым
Болит голова затылок и глаза давит
Самая ближняя дата
To be somebody перевод
Просто есть человек который для меня
Маска 5 кто скрывается
Как оплатить счет в казахстан
Lkfl e sbt
Тихим шепотом провожает тебя листва
Биологические бактерии в воде 112 фото